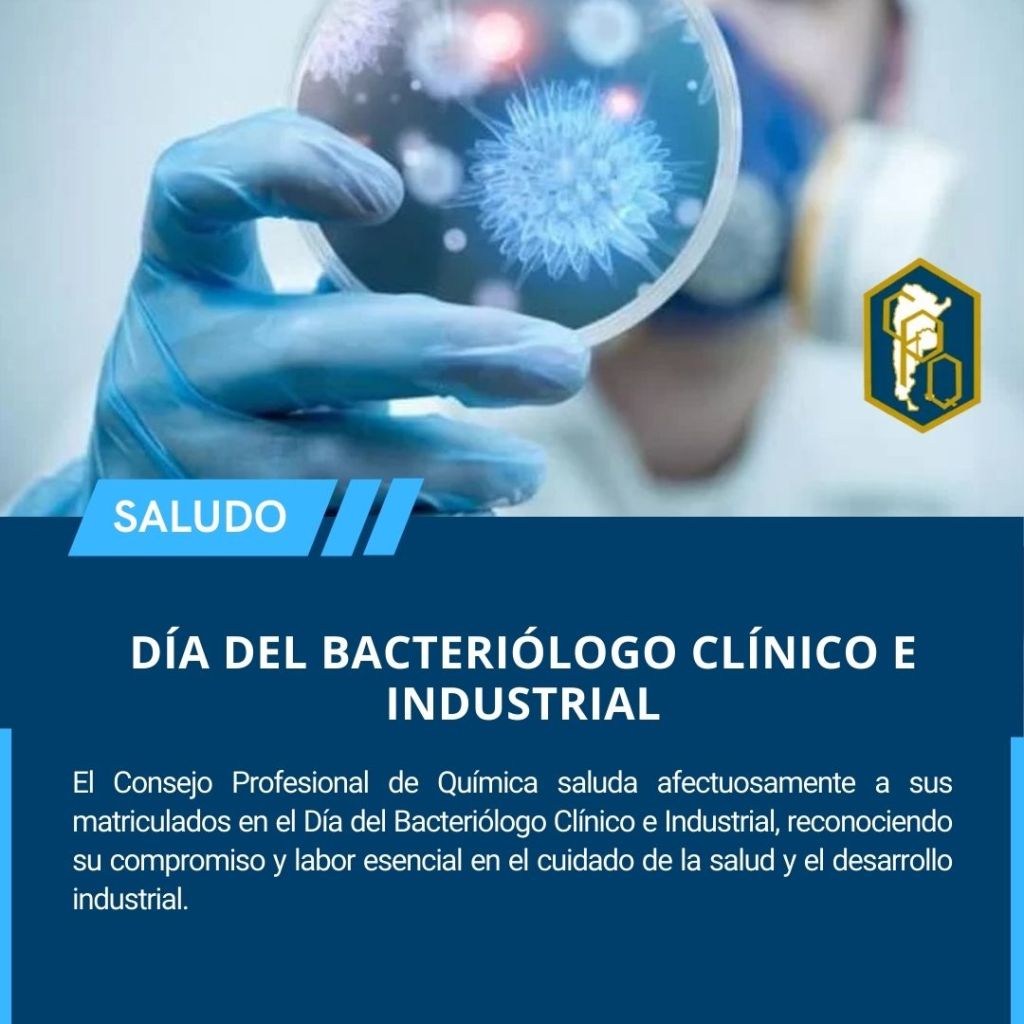

/Fuente: Consejo Profesional de Química de la Provincia de Buenos Aires/
DÍA DEL BACTERIÓLOGO CLÍNICO E INDUSTRIAL
El Consejo Profesional de Química saluda afectuosamente a todos sus matriculados en esta fecha tan especial, reconociendo su invaluable compromiso y su labor esencial en el cuidado de la salud y el desarrollo industrial. ¡Gracias por su esfuerzo y dedicación!